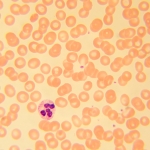
Биологичен цифров микроскоп MAGUS Bio D230T LCD

Биологичен цифров микроскоп MAGUS Bio D230T LCD

Информация
Magus Bio D230T LCD е тринокулярен биологичен микроскоп за лабораторни и изследователски наблюдения в областта на медицината, фармацевтиката, криминалистиката, биотехнологията и др. Подходящ е за наблюдение на плоски биологични полупрозрачни и прозрачни образци: тънки разрези и натривки. С оборудване от ахроматични обективи и халогенна крушка микроскопският метод с преминаваща светлина (метод на светлото поле) се използва за изследване на образци. Конструкцията на микроскопа предоставя възможност за монтиране на допълнителни принадлежности, които позволяват използването на други микроскопски методи: на тъмното поле, фазовоконтрастни наблюдения, с поляризирана светлина.
Цифрова камера
Камерата MAGUS CHD10 е оборудвана с 2 MP сензор и създава реалистични Full HD изображения с разделителна способност 1920x1080 пиксела.
Тя е автономна камера, която не изисква свързване с компютър или инсталиране на допълнителен софтуер. Камерата може да се свърже директно към телевизор, монитор или проектор, за да покаже изображение. Интерфейсът HDMI осигурява висока и стабилна скорост на предаване на данните от камерата към външния екран. Видеозапис се заснема с 60 fps.
Камерата комбинира висока честота на кадрите в секунда и широколентов HDMI. Поради това видеозаписите са ярки, няма „замръзвания“ или прекъсвания между кадрите. При максимална разделителна способност изображението е с добра детайлност, движещите се обекти се виждат без проблеми, а движението на обектите се показва без закъснения.
Течнокристален монитор
Мониторът MAGUS MCD20 е предназначен за използване на системата за визуализация на микроскопа MAGUS.
Той е свързан към камера, която е монтирана на микроскопа за показване на изображения в реално време. Поддържа HDMI камери MAGUS с разделителна способност Full HD.
Диагоналът на екрана е 13,3 инча. IPS матрицата осигурява ярки изображения при големи ъгли на видимост. Ако погледнете към дисплея под ъгъл, възпроизвеждането на цветовете не е нарушено.
Дисплеят може да се постави на сгъваема стойка върху маса или шкаф, или да се монтира директно към камерата или към стойката на микроскопа.
Оптика
Тринокулярната глава има специална вертикална тръба за монтиране на цифров фотоапарат в нея. Фотоапаратът (не е включен в комплекта) е отлично решение за създаване на цифров архив на вашите изследвания и извеждане на изображенията на екрана на външен монитор. За регулиране на наблюдателните тръби, така че да бъдат подходящи за височината на потребителя, има опция за завъртане на същите на 360°. Лявата тръба оборудвана с пръстен за регулиране на диоптъра.
Револверната глава е насочена навътре, което освобождава пространството над предметната маса. В револверната глава могат да се монтират едновременно пет обектива (4 обектива са включени в комплекта, а петият слот е оставен за допълнителен обектив). В базовата конфигурация коригираните до безкрайност обективи осигуряват увеличение от 40 до 1000x. Чрез допълнителни обективи горната граница може да бъде повишена до 1500, 1600, или 2000x.
Осветление
Халогенната крушка излъчва светлина в топлия спектър, която намалява напрежението на очите и е идеална за продължителна работа с микроскопа. Крушката е 30 W и поради това яркостта и контрастът на предаваното изображение са високи, независимо от вида на обектива или използвания метод за наблюдение.
Кондензерът на Abbe може да се настройва по височина и да се центрира. Осветлението се контролира чрез регулиране на ирисовата и полевата диафрагма, като има възможност за настройка на осветлението на Кьолер за по-ясно изображение. Кондензерът има слот за монтиране на плъзгач за фазоконтрастно наблюдение или такова по метода на тъмното поле, което ускорява процеса и улеснява превключването между различни микроскопски методи.
Предметна маса и механизъм за фокусиране
На предметната маса няма рейка за позициониране. Това е предимство на конструкцията на механичната предметна маса, понеже улеснява работата с микроскопа. Образецът може да се премества плавно по предметната маса. Механичното приспособление може да се маха (може да се демонтира за ръчно сканиране).
Има грубо и фино регулиране на фокуса, движението на бутона за регулиране е плавно и лесно и не изисква допълнително усилие. Грубото фокусиране има застопоряващ механизъм и бутон за регулиране на затягането. Бутоните за фокусиране са коаксиални, разположени са така, че да осигуряват максимален комфорт при продължително наблюдение и се намират на основата на микроскопа, така че да можете да опрете удобно ръцете си върху масата.
Принадлежности
За да увеличите максимално възможностите на микроскопа Magus Bio 230T, Вие можете да го надградите с някои принадлежности. Това може да включва окуляри и обективи, цифрови фотоапарати и калибрационни образци, кондензери за метода на тъмното поле, поляризирана светлина и устройства за фазовоконтрастно наблюдение.
Основни характеристики на микроскопа:
- Тринокулярна глава с вертикална тръба за монтиране на цифров фотоапарат
- Завъртането на 360° помага за регулиране на главата съобразно височината на наблюдаващия
- Ахроматични обективи с корекция до безкрайност, револверна глава за 5 обектива
- Пръстен за регулиране на диоптъра на лявата тръба
- Халогенна лампа 30 W с променливотоково захранване, кондензер на Abbe, слот за плъзгач за метода на тъмното поле и плъзгач за фазовоконтрастно наблюдение, полева диафрагма
- Бутони за грубо и фино фокусиране, застопоряващ бутон и бутон за регулиране на затягането
- Допълнителни принадлежности за подобряване на работните характеристики на микроскопа
Основни характеристики на камерата:
- Камерата работи автономно, без връзка с компютър или инсталиране на софтуер
- Интерфейс HDMI за висока и стабилна скорост на предаване на данни
- Разделителната способност на камерата е 1920x1080 pix – идеален избор за показване на изображения на Full HD монитор
- 60 fps за наблюдение на движещи се образци, заснемане на видеозаписи и преместване на образците без трептене или закъснения
- Цветният CMOS сензор SONY Starvis с фоново осветление осигурява ниско ниво на шума и висока светлочувствителност дори при слаба осветеност. Ще получите по-чисти, по-ярки изображения с по-наситени цветове
- Софтуер със заснемане на снимки и видеозаписи, редактиране, външен дисплей, линейни и ъглови измервания
Комплектът включва:
- Цифрова камера MAGUS CHD10 (цифрова камера, HDMI кабел (1,5 m), USB мишка, 32 GB SD карта с памет, променливотоков захранващ адаптер 12 V/1 A (Евро), ръководство за потребителя и гаранционна карта)
- Течнокристален монитор MAGUS MCD20
- Основа с вход за захранване, светлинен източник за преминаваща светлина, механизъм за фокусиране, предметна маса, кондензер и револверна глава
- Тринокулярна глава
- Ахроматичен обектив с корекция до безкрайност: 4x/0,1
- Ахроматичен обектив с корекция до безкрайност: 10x/0,25
- Ахроматичен обектив с корекция до безкрайност: 40x/0,65 (пружинно натоварен)
- Ахроматичен обектив с корекция до безкрайност: 100x/1,25 (пружинно натоварен)
- Окуляри 10x/18 mm с голямо разстоянието от очите (2 бр.)
- Чашки на окулярите (2 бр.)
- Филтри (4 бр.)
- Адаптер за камера с С-образна монтировка
- Бутилка с имерсионно масло
- Шестостенен ключ
- Променливотоково захранване
- Покривало против прах
- Ръководство за потребителя и гаранционна карта
Предлагат се по заявка:
- Окуляр 15x/11 mm (2 бр.)
- Окуляр 16x/11 mm (2 бр.)
- Окуляр 20x/11 mm (2 бр.)
- Ахроматичен обектив с корекция до безкрайност: 20x/0,4
- Фазовоконтрастно устройство
- Плъзгач за фазовоконтрастно наблюдение
- Кондензер за тъмно поле NA 0,9
- Кондензер за метода на тъмното поле в имерсионно масло NA 1,36–1,25
- Плъзгач за метода на тъмното поле
- Устройство за поляризация
- Калибрационен образец
| Марка | MAGUS |
| Гаранция, години | 5 |
| EAN | 5905555017952 |
| Размер на опаковката (Д x Ш x В), cm | 43.1x27.1x63 |
| Транспортно тегло, kg | 12.65 |
| Глава | тринокулярни |
| Ъгъл на наклон на главата | 30 ° |
| Диапазон на увеличението | от 800x до 1280x |
| Диаметър на тръбата на окуляра, mm | 23.2 |
| Обективи | ахроматични с корекция до безкрайност: 4x/0,1 10x/0,25 40xs/0,65 100xs/1,25 (масло) парфокално разстояние 45 mm (*опция: 20x/0,4) |
| Револверна глава | за 5 обектива |
| Работна дистанция, mm | 18,89 (4x) 5,95 (10x) 0,775 (40xs) 0,36 (100xs) 2,61 (20х) |
| Разстояние между окулярите, mm | 48 — 75 |
| Предметна маса, mm | 180x150 |
| Диапазон на движение на предметната маса, mm | 75/50 |
| Регулиране на диоптъра на окуляра, диоптри | ±5 (на лявата тръба) |
| Кондензатор | кондензер Abbe, N.A. 1,25, с регулируем център, регулируема височина, диафрагма с регулируема апертура, слот за плъзгач за метода на тъмното поле и плъзгач за фазовоконтрастно наблюдение, монтировка тип „лястовича опашка“ |
| Диафрагма | диафрагма с регулируема апертура, полева диафрагма с регулируем ирис |
| Фокусиране | коаксиален, грубо фокусиране (21 mm, 39,8 mm/кръг, със застопоряващ бутон и бутон за регулиране на затягането) и фино фокусиране (0,002 mm) |
| Регулиране на яркостта | yes |
| Тип на светлинния източник | халогенна крушка 12 V/30 W, G4 |
| Диапазон на работната температура,°C | 5 — 35 |
| Ниво на трудност на сглобяване и монтаж | сложен |
| Място на осветлението | долно |
| Тегло, kg | 8 |
| Размери, mm | 200x436x400 |
| Сензор | SONY Starvis CMOS |
| Цветен/монохромен | цветен |
| Мегапиксела | 2 |
| Максимална разделителна способност, пиксели | 1920x1080 |
| Размер на сензора | 1/2,8' (5,57x3,13mm) |
| Размер на пиксела, μm | 2.9x2.9 |
| Светлочувствителност | 1300 mV при 1/30 s |
| Време за експозиция | 0,04 ms – 1000 ms |
| Видеозапис | yes |
| Формат на изображението | *.jpg |
| Спектрален диапазон, nm | 380–650 (вграден инфрачервен филтър) |
| Тип на затвора | ERS (електронен преместващ се затвор) |
| Изисквания към системата | не изисква връзка с компютър |
| Тип на монтажа | C-образна монтировка |
| Захранване на камерата | променливотоков адаптер 12 V, 1 A |
| Диапазон на работната температура на камерата, °С | -10 — 50 |
| Диапазон на работната влажност, % | 30 — 80 |
| Тип | биологичен, светлина/оптичен, цифрови |
| Глава | глава Gemel (Siedentopf, завъртане на 360°) |
| Увеличение, x | 40–1000 при базовата конфигурация (*опция: 40–1500/1600/2000) |
| Окуляри | 10x/18 mm, разстояние от очите: 10 mm (*опция: 15x/11 mm, 16x/11 mm 20x/11 mm) |
| Характеристики на предметната маса | двуосова механична предметна маса, без рейка за позициониране |
| Осветление | халогенно |
| Захранване | 220±22 V, 50 Hz, променливотокова мрежа |
| Светлинни филтри | да |
| Възможност за свързване на допълнително оборудване | фазовоконтрастно устройство (кондензер и обективи), кондензер за метода на тъмното поле в имерсионно масло (сух или в масло), устройства за поляризация (поляризатор и анализатор) |
| Потребителско ниво | опитни потребители, за професионалисти |
| Приложение | лабораторно/медицинско |
| Метод за изследване | на светлото поле |
| Торбичка/калъф/чанта в комплект | покривало против прах |
| Интерфейсни съединители | HDMI 1,4 |
| Карта с памет | SD до 32 GB |
| Възможност за свързване на допълнително оборудване | USB мишка |
| Място на монтаж | тринокулярна тръба, окулярна тръба вместо окуляр |
| Видео формат | *.h264, *.mp4 |
| Тяло | плътен алуминий |
| Софтуер | HDMI: вграден |
| Спецификации на променливотоковия захранващ адаптер | входни параметри: променливо напрежение 100–240 V, 50/60 Hz, изходни параметри: постоянно напрежение 12 V/1 A |

Отзиви към продукт